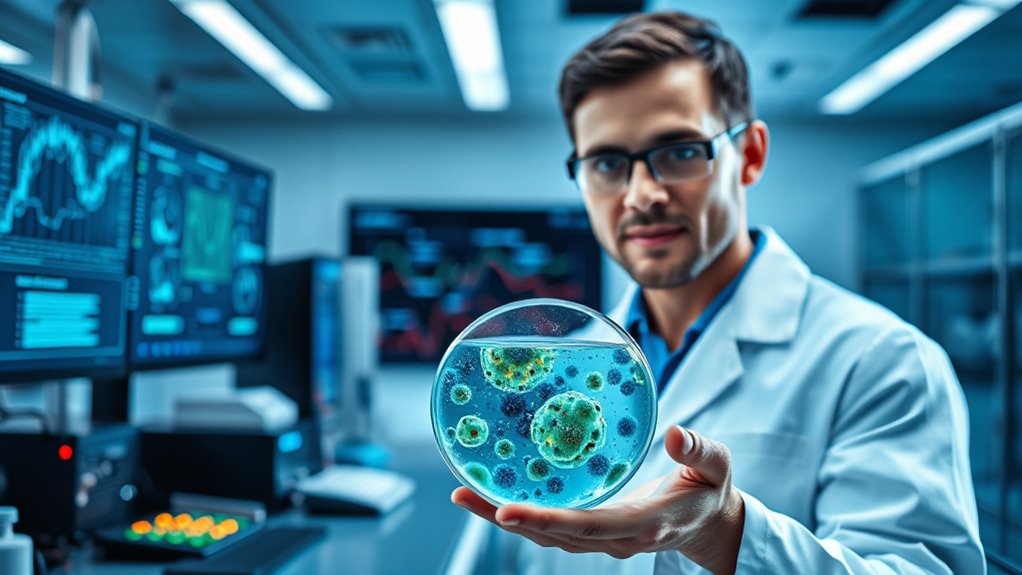

Recent clinical trials for universal flu vaccines show promising results, indicating they could offer broad, long-lasting protection against various influenza strains. These vaccines target conserved parts of the virus, aiming to reduce the need for annual shots and provide more reliable immunity. If successful, they could greatly decrease flu-related illness and burdens on healthcare systems. Keep exploring to discover how these advances might reshape flu prevention in the future.
Key Takeaways
- Early clinical trials demonstrate that universal flu vaccines can induce broad, cross-strain immune responses.
- Results indicate these vaccines recognize conserved viral regions, offering potential long-lasting protection.
- Participants in trials show promising safety profiles alongside immune durability.
- Such vaccines could reduce the need for annual flu shots by targeting multiple strains simultaneously.
- Ongoing research aims to refine formulations and confirm efficacy before widespread deployment.

Have you ever wondered if a single flu vaccine could protect you year after year? That’s exactly what researchers are working toward with the development of a universal flu vaccine. Unlike the seasonal vaccines you get each year, which target specific strains predicted to circulate, a universal vaccine aims to offer broad and lasting protection against various influenza viruses. This goal is a substantial leap in vaccine development, promising to reduce the need for annual shots and improve public health outcomes worldwide. The challenge lies in creating a vaccine that can effectively target conserved parts of the virus, which don’t change much from year to year, instead of the highly variable regions that make seasonal vaccines less effective over time.
Early clinical trials for these universal vaccines are showing promising results. Researchers are testing different formulations to see which can elicit a strong and durable immune response across multiple flu strains. These trials involve volunteers receiving the vaccine and then being monitored for their immune response and safety. So far, the data indicates that some candidates can generate broad immunity, meaning your body recognizes and fights off a wide array of influenza viruses, not just the specific strains included in the vaccine. This broad protection could be a game-changer, especially during seasons when unpredictable or emerging strains cause widespread illness. Additionally, vaccine efficacy depends on targeting the right conserved regions of the virus to ensure long-lasting protection.
Early trials show universal flu vaccines can generate broad immunity across multiple strains.
The potential impact on public health could be enormous. Each year, millions of people worldwide suffer from flu-related complications, hospitalizations, and deaths. A universal flu vaccine could considerably reduce these numbers by providing consistent, long-lasting immunity. It also simplifies the logistics of vaccination programs. Instead of annual campaigns that require careful prediction and manufacturing, health authorities could deploy a single, effective vaccine that covers multiple seasons. This would be especially beneficial for vulnerable populations such as the elderly, young children, and those with compromised immune systems, who are most at risk from the flu.
However, it’s important to remember that these vaccines are still in early trial phases. Researchers are working diligently to refine formulations, improve efficacy, and ensure safety before widespread use. While the early results are encouraging, it might still take a few years before a universal flu vaccine becomes part of routine immunization programs. Nonetheless, these advancements mark a substantial step forward in vaccine development and public health, bringing us closer to a future where a single shot could offer lasting protection against influenza every year.

Pale Rider: The Spanish Flu of 1918 and How It Changed the World
Orders are despatched from our UK warehouse next working day.
As an affiliate, we earn on qualifying purchases.
As an affiliate, we earn on qualifying purchases.
Frequently Asked Questions
How Soon Could This Vaccine Be Available to the Public?
You might have the universal flu vaccine within a few years, but it depends on completing clinical trials and regulatory approval. As vaccine distribution plans develop, healthcare providers will prioritize widespread access. Staying informed about public awareness campaigns helps you prepare for when it becomes available. While there’s optimism, it’s best to follow official updates to know exactly when you can get protected against various flu strains.
Will the Vaccine Be Effective Against All Flu Strains?
The vaccine aims to be effective against most flu strains by targeting conserved regions, which helps address strain variability. While it may not protect against every single strain, it offers broad immune coverage, reducing the need for annual updates. You can expect it to provide significant protection against a wide range of circulating flu viruses, but some strain differences might still influence individual effectiveness.
Are There Any Known Side Effects From the Vaccine?
You’ll be glad to know that vaccine safety is a top priority, and early trials show a favorable side effect profile. Most people experience mild reactions like soreness or fatigue, which usually pass quickly. Serious side effects are rare, and ongoing testing aims to guarantee the vaccine’s safety for widespread use. Rest assured, researchers are carefully monitoring all data to confirm that the vaccine remains both effective and safe for everyone.
How Does This Vaccine Differ From Current Flu Shots?
Imagine you’re in the year 2099, and this vaccine is like a futuristic device. Unlike current flu shots, it offers broader strain coverage, targeting multiple flu strains with a single shot. It aims to stimulate a stronger, more all-encompassing immune response, reducing the need for annual updates. This means you’re better protected against diverse flu viruses, making it a game-changer compared to traditional vaccines that mostly target specific strains each year.
What Are the Next Steps in the Vaccine’s Clinical Development?
Your next steps involve animal testing to guarantee safety and efficacy. Researchers will focus on dosage optimization to determine the most effective amount for humans. After successful animal trials, you’ll see clinical trials progressing through phases to assess safety, dosage, and effectiveness in people. This careful process ensures the vaccine is both safe and potent before it becomes widely available, bringing you closer to better flu protection.

Elixir Shots, Vitality Cold-Pressed Shot for Healthy Digestion and Overall Daily Balance with 100% Organic Ingredients, Red Hawaiian Turmeric, Peruvian Ginger, Pineapple, and Lemon, No Sugar or Artificial Additives, 12 Pack
SUPER POTENT – We get our Turmeric from our Family Farm in Kauai that does Regenerative farming. We…
As an affiliate, we earn on qualifying purchases.
As an affiliate, we earn on qualifying purchases.
Conclusion
This universal flu vaccine offers hope for a healthier future. It promises protection across seasons, protection across strains, and protection across generations. It simplifies prevention, reduces risks, and saves lives. By embracing this innovation, you embrace a future where flu seasons no longer threaten your well-being. Stay hopeful, stay informed, and stay prepared—because with this vaccine, a healthier tomorrow is within reach for everyone.
long-lasting influenza vaccine
As an affiliate, we earn on qualifying purchases.
As an affiliate, we earn on qualifying purchases.
conserved viral region flu vaccine
As an affiliate, we earn on qualifying purchases.
As an affiliate, we earn on qualifying purchases.